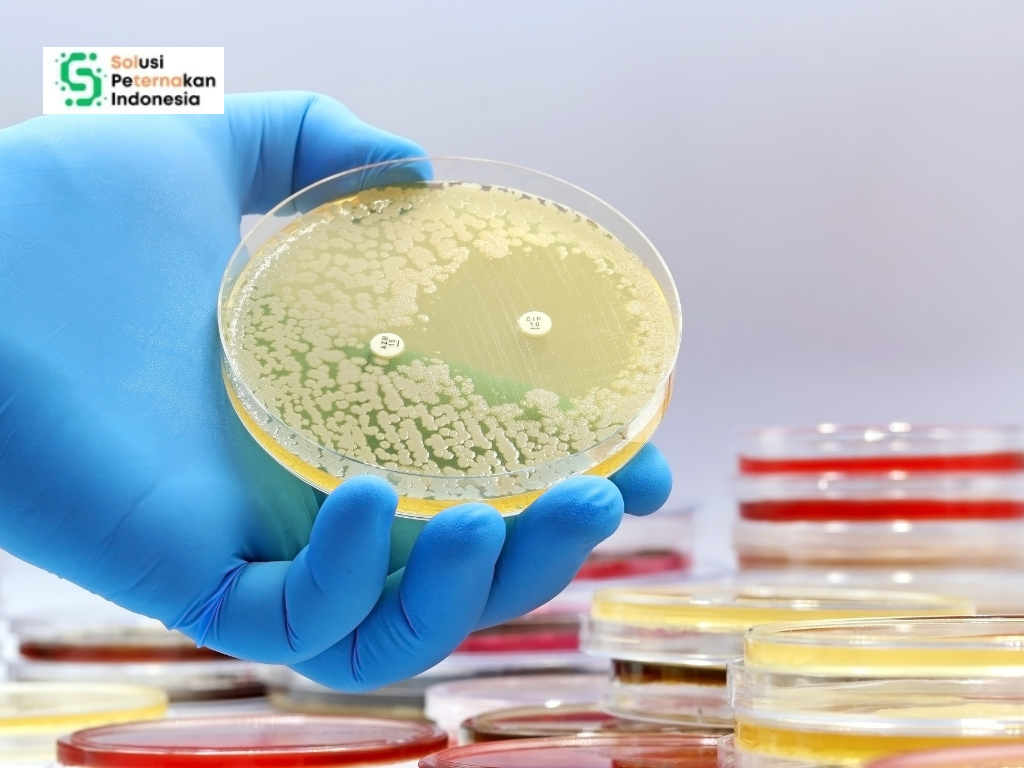

Peternakan modern memainkan peran penting dalam memenuhi kebutuhan pangan dunia, terutama protein hewani seperti daging, susu, dan telur. Namun, di balik manfaat besar tersebut, muncul tantangan serius yang jarang disadari masyarakat luas, yaitu pencemaran lingkungan akibat penggunaan antibiotik. Penelitian terbaru dari wilayah Daerah Aliran Sungai Damodar di India membuka mata kita tentang bagaimana aktivitas manusia, termasuk peternakan, dapat meninggalkan jejak obat-obatan di air tanah yang selama ini dianggap aman.
Antibiotik telah lama digunakan dalam dunia peternakan. Peternak memanfaatkannya untuk mengobati penyakit, mencegah infeksi, dan dalam beberapa kasus untuk mempercepat pertumbuhan ternak. Praktik ini memang membantu menjaga produktivitas, tetapi penggunaan yang berlebihan dan tidak terkontrol menimbulkan dampak lanjutan yang berbahaya. Salah satu dampaknya adalah masuknya sisa antibiotik ke lingkungan melalui kotoran ternak, yang kemudian meresap ke tanah dan mencemari air tanah.
Baca juga artikel tentang: Glukosinolat di Camelina: Tantangan Kimia untuk Masa Depan Peternakan Berkelanjutan
Air tanah merupakan sumber air bersih utama bagi jutaan orang, terutama di daerah pedesaan. Banyak masyarakat mengandalkan sumur untuk minum, memasak, dan kebutuhan sehari-hari. Ketika air tanah tercemar antibiotik, risiko kesehatan pun meningkat. Penelitian di wilayah Sungai Damodar menemukan setidaknya dua belas jenis antibiotik berbeda di dalam air tanah. Temuan ini menunjukkan bahwa pencemaran bukan lagi dugaan, melainkan fakta yang terukur secara ilmiah.
Beberapa antibiotik yang paling sering ditemukan antara lain eritromisin, sulfadiazin, dan doksisiklin. Zat-zat ini berasal dari berbagai sumber, mulai dari limbah rumah tangga, rumah sakit, industri, hingga limbah peternakan. Dalam konteks peternakan, antibiotik yang dikonsumsi ternak tidak sepenuhnya diserap oleh tubuh hewan. Sebagian besar dikeluarkan kembali melalui urin dan feses, lalu mencemari tanah jika limbah tidak dikelola dengan baik.

Masalahnya tidak berhenti pada pencemaran air. Antibiotik yang terus-menerus berada di lingkungan dapat memicu munculnya bakteri yang kebal obat. Bakteri resisten antibiotik ini berbahaya karena dapat menyebabkan penyakit yang sulit diobati pada manusia maupun hewan. Anak-anak menjadi kelompok yang paling rentan karena sistem kekebalan tubuh mereka masih berkembang. Penelitian menunjukkan bahwa beberapa jenis antibiotik tertentu memiliki dampak kesehatan yang lebih besar pada anak dibandingkan orang dewasa.
Selain dampak kesehatan manusia, ekosistem juga ikut terdampak. Air tanah yang mengandung antibiotik dapat mengalir ke sungai dan danau, memengaruhi organisme air seperti alga dan mikroorganisme. Gangguan pada organisme kecil ini dapat merusak rantai makanan dan keseimbangan ekosistem secara keseluruhan. Dengan kata lain, pencemaran antibiotik bukan hanya masalah kesehatan, tetapi juga masalah lingkungan dan keberlanjutan.
Lalu apa kaitannya dengan sektor peternakan secara langsung. Peternakan merupakan salah satu sumber utama antibiotik lingkungan, terutama di wilayah dengan kepadatan ternak tinggi. Ketika kotoran ternak dibuang langsung ke lahan tanpa pengolahan, antibiotik di dalamnya dengan mudah meresap ke tanah. Jenis tanah, tingkat keasaman, dan kondisi air tanah sangat memengaruhi seberapa cepat dan seberapa jauh antibiotik tersebut menyebar.
Penelitian di India menunjukkan bahwa daerah dengan aktivitas industri dan peternakan intensif memiliki tingkat pencemaran tertinggi. Hal ini menegaskan bahwa pengelolaan limbah menjadi kunci utama pencegahan. Peternakan yang tidak dilengkapi sistem pengolahan kotoran yang baik berpotensi menjadi sumber pencemaran jangka panjang, bahkan ketika aktivitasnya sudah berhenti.
Kabar baiknya, masalah ini masih bisa dicegah dan dikendalikan. Salah satu langkah penting adalah penggunaan antibiotik secara bijak di peternakan. Antibiotik seharusnya hanya digunakan untuk pengobatan, bukan sebagai pencegahan rutin atau pemacu pertumbuhan. Banyak negara mulai menerapkan aturan ketat terkait penggunaan antibiotik pada hewan ternak, dan hasilnya menunjukkan penurunan risiko resistensi.
Selain itu, pengelolaan limbah peternakan perlu ditingkatkan. Teknologi seperti pengomposan, biogas, dan pengolahan anaerob dapat membantu mengurai residu antibiotik sebelum limbah dibuang ke lingkungan. Praktik ini tidak hanya mengurangi pencemaran, tetapi juga menghasilkan manfaat tambahan berupa pupuk organik dan energi terbarukan.
Edukasi peternak juga memegang peran penting. Peternak perlu memahami bahwa penggunaan antibiotik yang berlebihan dapat merugikan mereka sendiri dalam jangka panjang. Penyakit yang kebal obat akan meningkatkan biaya pengobatan dan menurunkan produktivitas ternak. Dengan menerapkan manajemen kesehatan hewan yang baik, kebersihan kandang, dan nutrisi seimbang, kebutuhan antibiotik sebenarnya dapat ditekan.
Bagi konsumen, kesadaran juga perlu ditingkatkan. Memilih produk peternakan dari sumber yang bertanggung jawab dapat mendorong praktik peternakan yang lebih ramah lingkungan. Tekanan pasar sering kali menjadi pemicu perubahan yang efektif ketika kebijakan berjalan lambat.
Penelitian tentang antibiotik di air tanah ini memberi pesan penting bahwa sektor peternakan tidak berdiri sendiri. Aktivitas di kandang ternak dapat berdampak jauh hingga ke sumur air minum masyarakat. Oleh karena itu, pembangunan peternakan berkelanjutan harus memikirkan kesehatan manusia, hewan, dan lingkungan secara bersamaan.
Peternakan masa depan tidak hanya diukur dari jumlah produksi, tetapi juga dari dampaknya terhadap lingkungan dan kesehatan publik. Dengan pengelolaan antibiotik yang bijak, teknologi limbah yang tepat, dan kesadaran bersama, sektor peternakan dapat tetap produktif tanpa mengorbankan kualitas air dan keselamatan generasi mendatang.
Baca juga artikel tentang: Perisai Air Tanah: Bagaimana PRB Menjadi Penjaga Lingkungan Peternakan
REFERENSI:
Seal, Kankana dkk. 2026. Accumulation of antibiotics in groundwater of the damodar river basin, India and health risk prediction: source identification and linkage with hydrochemistry. Environmental Geochemistry and Health 48 (1), 1.